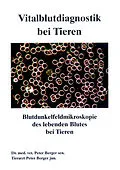

Beschreibung
Die Vitalblutdiagnostik bei Tieren ist eine frühdiagnostische Methode für die Differentialdiagnose bestimmter definierter Erkrankungen. Sie ist geeignet für Tierärzte, die in der Regulationsmedizin (Homöopathie, Homotoxikologie, Isopathie) Erfahrungen besitzen...